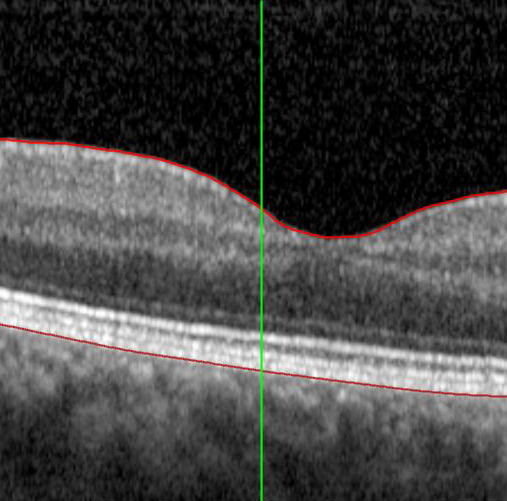
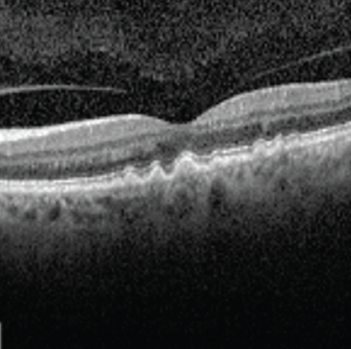
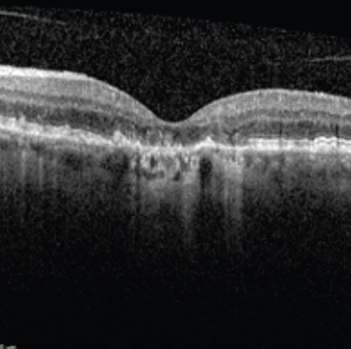

Dr David Maberley
Président et chef du Département d’ophtalmologie
Université d’Ottawa
L’Hôpital d’Ottawa, Ottawa (Ontario)
Le Dr David Maberley est un spécialiste de la rétine à l’Hôpital d’Ottawa. Il prodigue des soins médicaux et chirurgicaux aux patients qui ont été dirigés vers lui pour un éventail de maladies de la rétine, dont la DMLA. Pour le Dr Maberley, l’aspect le plus gratifiant du traitement des patients atteints de DMLA est de pouvoir leur donner l’assurance qu’avec un traitement, la vision peut souvent être stabilisée et, dans certains cas, améliorée.
Qu’est-ce que la DMLA?
La DMLA est une maladie qui touche la rétine et, plus précisément, la macula. La rétine est une structure au fond de l’œil faite de tissu sensible à la lumière. Elle agit comme la pellicule d’un appareil photo; elle convertit la lumière en un signal que le cerveau interprète comme une image. Au centre de la rétine se trouve une petite zone appelée macula, qui nous permet de distinguer nettement les menus détails. Une couche de cellules située sous la rétine la nourrit et lui permet de fonctionner sainement. Cette couche de cellules se nomme épithélium pigmentaire rétinien.
La DMLA est une détérioration ou un affaiblissement des cellules de la macula, ce qui provoque une perte de vision centrale. Les personnes atteintes de DMLA perdent l’acuité de la vision centrale nécessaire pour des activités comme conduire, lire et reconnaître les visages.

Quelle est la différence entre la DMLA humide et sèche?
Afin de comprendre les deux types de DMLA, vous pouvez imaginer que la rétine et les cellules sous-jacentes sont un trottoir. Au départ, il s’agit d’un trottoir lisse et pavé, mais au fil des décennies, il commence à se fissurer et à s’effriter. C’est ce qui se produit dans le cas de la DMLA sèche. Les cellules de la rétine commencent à se détériorer. Les symptômes de la perte de vision surviennent graduellement et s’aggravent lentement avec le temps.

Il arrive parfois que de petits arbres poussent à travers les fissures du trottoir. Ils peuvent écarter les bords du trottoir et causer beaucoup de dégâts en peu de temps. C’est ce qui arrive à l’œil dans le cas de la DMLA humide. Des vaisseaux sanguins peuvent commencer à se développer dans des zones affaiblies sous la rétine externe. Ces vaisseaux laissent fuir du liquide et du sang, ce qui provoque des gonflements et des cicatrices, qui entraînent une perte de vision. Parce que les dommages qu’elle cause surviennent relativement vite, la DMLA humide provoque une perte de vision plus soudaine comparativement à la DMLA sèche.

Je suis une femme dans la fin de la cinquantaine. Comment puis-je réduire mes risques de développer la DMLA?
C’est formidable que vous soyez proactive à propos de votre santé oculaire. Toutefois, concernant la DMLA, les plus importants facteurs de risque sont largement hors de notre contrôle. Le plus important facteur de risque est l’âge; la DMLA commence habituellement à se développer chez les personnes âgées de plus de 70 ans. Nous savons également qu’environ 80 % des cas de DMLA sont causés par une prédisposition génétique.
Vous pourriez également être plus susceptible de développer la DMLA si vous :
- Fumez
- Avez une alimentation riche en gras saturés
- Êtes atteinte de maladies chroniques comme l’obésité ou l’hypertension
Le fait de cesser de fumer, d’avoir une saine alimentation (qui comprend des aliments riches en antioxydants et acides gras oméga-3), de faire régulièrement de l’exercice et de contrôler d’autres problèmes de santé peut contribuer à réduire votre risque de développer la DMLA.
Même si vous ne pouvez pas contrôler tous les facteurs de risque, la meilleure façon de protéger votre vision contre la DMLA est de passer régulièrement des examens de la vue complets, afin que l’on puisse détecter et traiter rapidement la DMLA.


La Dre Setareh Ziai, ophtalmologiste, donne d’autres conseils sur le mode de vie afin de maintenir une bonne santé oculaire.
Mon optométriste a remarqué des changements à ma rétine. J’ai été dirigé vers un ophtalmologiste pour vérifier si je suis atteint de DMLA. À quoi puis-je m’attendre de mon rendez-vous à venir?
Le fait que vous ayez été dirigé vers un ophtalmologiste vous permettra d’obtenir un diagnostic formel de DMLA (ou d’éliminer d’autres affections pouvant affecter votre rétine). Les évaluations habituelles pour détecter la DMLA incluent un test de vision et un examen de la vue complet, y compris un examen de la rétine. De plus, vous devrez probablement passer un examen d’imagerie appelé tomographie par cohérence optique (TCO). Il s’agit d’un balayage laser non invasif du fond de l’œil. Il permet à votre ophtalmologiste de voir des zones de la rétine pouvant être endommagées ou en train de mourir et vérifier la présence de vaisseaux sanguins anormaux. Sur la base de ce que constate votre ophtalmologiste avec ces examens, d’autres examens d’imagerie pourraient être nécessaires.

Une fois le diagnostic établi, votre ophtalmologiste pourra vous faire des recommandations de traitement et, le cas échéant, commencer le traitement. Selon l’endroit où vous habitez et la complexité de votre cas, on pourrait également vous diriger vers un spécialiste de la rétine qui s’occupera de vos soins.
Comment fonctionnent les traitements de la DMLA pour prévenir la perte de vision?
Dans le cas de la DMLA humide, une protéine appelée facteur de croissance de l’endothélium vasculaire (VEGF) favorise la croissance de vaisseaux sanguins anormaux sous la macula. Ces vaisseaux sanguins peuvent laisser fuir du liquide et du sang, formant ainsi un tissu cicatriciel sous la rétine, ce qui entraîne une perte de vision permanente. La bonne nouvelle est que nous disposons de médicaments appelés anti-VEGF qui ciblent ces vaisseaux sanguins anormaux. Les anti-VEGF freinent la croissance et la fuite des vaisseaux sanguins et provoquent le rétrécissement et la disparition des vaisseaux sanguins anormaux, empêchant ainsi toute perte de vision supplémentaire. À mesure que le liquide autour de ces vaisseaux sèche, les symptômes de perte de vision peuvent même s’atténuer.
Malheureusement, il n’existe toujours pas de traitement médical pour la DMLA sèche. Un traitement par des vitamines précises à doses élevées appelé AREDS 2 est utilisé depuis longtemps chez les personnes atteintes de DMLA sèche. Les données probantes suggèrent qu’il peut ralentir l’évolution de la maladie. Il a également été démontré qu’il réduisait le risque que la DMLA sèche évolue vers une DMLA humide. Si vous êtes atteint de DMLA sèche, demandez à votre ophtalmologiste si les suppléments de vitamines suivant la formule AREDS 2 pourraient être avantageux pour vous. Santé Canada étudie actuellement un traitement par injection qui pourrait ralentir la progression de l’atrophie géographique (DMLA sèche à un stade avancé). Ce traitement sera vraisemblablement disponible au milieu ou à la fin de 2024.
Je dois recevoir la semaine prochaine ma première injection d’anti-VEGF pour traiter la DMLA humide. Que se passera-t-il exactement durant cette intervention?
Les médicaments anti-VEGF sont administrés par injection intravitréenne, une intervention utilisée pour placer le médicament directement dans l’espace au fond de l’œil appelé cavité vitréenne. L’intervention sera réalisée par votre ophtalmologiste ou un spécialiste de la rétine dans son cabinet, et le processus dans son ensemble ne dure que de 5 à 10 minutes.
Votre ophtalmologiste engourdira votre œil et votre paupière à l’aide de gouttes ophtalmiques anesthésiques ou un gel pour réduire la douleur. Il nettoiera ensuite l’œil pour minimiser le risque d’infection. Le médicament anti-VEGF sera injecté dans le blanc de l’œil avec une aiguille très fine. Vous pourriez ressentir une certaine pression ou un inconfort au moment de l’injection, et vous pourriez également ressentir une brève douleur aiguë.
Même si les anti-VEGF provoquent peu d’effets secondaires et que les complications sont rares, un petit risque d’infection est toujours présent. Si vous constatez une douleur qui s’aggrave ou une rougeur qui se développe quelques jours après votre injection, téléphonez au cabinet de votre ophtalmologiste.


Ma mère m’a mentionné qu’elle avait remarqué que sa vision était trouble. S’agit-il seulement d’un aspect normal du vieillissement?
Je crois qu’il est essentiel que tous comprennent que la perte de vision avec l’âge n’est pas normale. Si vous constatez une détérioration ou un changement soudain à votre vision, il est très probable qu’une affection oculaire soit en cause et qu’elle puisse être traitée.
Puisque la DMLA est la principale cause de cécité au Canada, il est important d’avoir conscience du risque en vieillissant. Tous les adultes de plus de 65 ans devraient passer un examen de la vue complet au moins chaque année afin que l’on puisse détecter tout signe de DMLA (ou d’autres maladies oculaires graves) et entamer un traitement précoce avant qu’une perte de vision ne se produise. Si vous développez des symptômes visuels, par exemple une vision trouble ou déformée ou des plaques de perte de vision, ne les ignorez pas – faites-vous examiner immédiatement.
« Le fait de vieillir ne signifie pas perdre la vue. Il y a tant de choses que nous pouvons offrir pour que la plupart des gens puissent continuer à voir tout au long de leur vie. »
Je viens de recevoir un diagnostic de DMLA humide. Pendant combien de temps aurai-je besoin de traitements?
Le traitement de la DMLA humide nécessite un engagement à long terme. Dans mes discussions avec mes propres patients atteints de DMLA, j’insiste toujours sur l’importance de suivis constants. Habituellement, après les premières injections mensuelles, les médicaments anti-VEGF sont administrés moins fréquemment. Bien souvent, il ne faut les administrer que tous les deux ou trois mois. Il est possible de raccourcir ou de prolonger le délai entre les injections selon l’état du patient, mais vous devrez vraisemblablement suivre un traitement relativement intensif avec votre ophtalmologiste pendant quelques années. Même lorsque nous arrivons à contrôler la dégénérescence maculaire et que l’on arrive à diminuer la fréquence de vos injections – voire même les arrêter –, il existe toujours un risque de récurrence et la nécessité d’exercer une surveillance continue.


Je suis atteint de DMLA sèche à un stade avancé et j’ai déjà subi une perte de vision. Peut-on faire quelque chose de plus?
À l’heure actuelle, il n’existe pas de traitement pouvant inverser les dommages causés par une DMLA humide ou sèche à un stade avancé. Mais pour les personnes qui se retrouvent avec une perte de vision permanente, il est important qu’elles comprennent que nous disposons d’outils que nous pouvons leur offrir, même s’il n’y a rien d’autre à faire d’un point de vue thérapeutique. La thérapie visuelle est un domaine de soins spécialisés en ophtalmologie qui évolue rapidement et qui permet aux gens de mieux fonctionner avec la vision qui leur reste. Les traitements peuvent inclure le grossissement ou une formation pour montrer aux patients à se servir des zones de leur rétine qui sont encore fonctionnelles. Cette thérapie fournit aux patients des stratégies et appareils permettant d’optimiser la vision qui leur reste et d’améliorer leur capacité à se débrouiller dans leur vie quotidienne. On peut accomplir beaucoup avec des technologies comme les logiciels de synthèse vocale, les loupes, les lunettes télescopiques et les téléviseurs en circuit fermé pour aider les personnes ayant une perte de vision à mener une vie plus autonome et active. Si vous avez une basse vision en raison de la DMLA ou d’une autre maladie oculaire grave, discutez avec votre ophtalmologiste à propos d’un aiguillage vers une clinique de thérapie visuelle.
Quelles sont les recherches réalisées actuellement sur la DMLA?
Il s’agit certainement d’une période formidable pour la DMLA, avec à l’horizon des innovations qui amélioreront les soins de la DMLA au Canada. Dans le cas de la DMLA humide, on procède à la mise au point de médicaments anti-VEGF de prochaine génération qui pourraient être plus durables que les options actuellement offertes. Cela signifie que les patients n’auraient pas besoin de recevoir des injections aussi fréquemment. Nous prévoyons également la commercialisation prochaine de nouveaux traitements pour l’atrophie géographique (AG) – une forme de DMLA sèche à un stade avancé actuellement non traitable. L’AG provoque une perte complète des photorécepteurs, d’abord par plaques, puis dans toute la macula. Des essais cliniques ont démontré des résultats prometteurs pour ralentir l’évolution de cette forme de DMLA sèche.
D’autres types de thérapies en sont aux premiers stades de la recherche. La thérapie génique est à l’étude pour aider l’œil à fabriquer son propre anti-VEGF qui empêcherait la maladie de s’aggraver. Vous pourriez également avoir entendu parler de la thérapie à l’aide de cellules souches comme moyen de remplacer les cellules rétiniennes endommagées. Ces greffes de cellules pourraient possiblement « repaver le trottoir », si vous voulez. Les études en sont à un stade très précoce, et cette option de traitement n’est pas encore pour demain.
D’autres domaines de progrès sont le diagnostic et le suivi. L’autofluorescence du fond d’œil (AF) est une technique d’imagerie utile pour obtenir une définition plus claire des zones de cellules endommagées dans les cas de DMLA sèche. Les images peuvent être associées à des algorithmes d’IA pour aider à suivre l’évolution de la maladie et surveiller la croissance des lésions. Lorsque cette technologie d’apprentissage automatique sera largement accessible à l’échelle clinique, elle nous fournira un autre outil pour surveiller les formes avancées de DMLA.

Des technologies de surveillance peu coûteuses qui détectent une vision déformée font également l’objet d’études dans le cadre d’essais cliniques. Ces appareils pourraient être utilisés au domicile des patients, et les données seraient transmises directement à leur ophtalmologiste afin que les plans de suivi puissent être ajustés en conséquence.
Grâce à ces technologies et à d’autres avancées prometteuses, l’avenir de la prise en charge de la DMLA s’annonce positif.